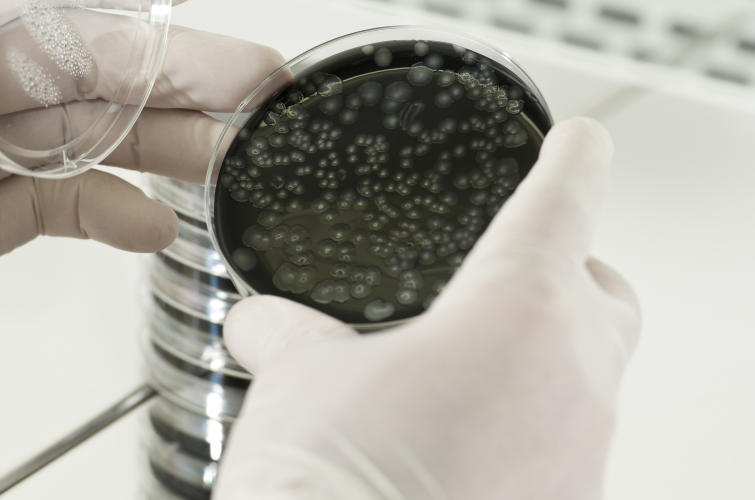

Legionella: Controllo contaminazione dell'acqua
SERVIZI DI ANALISI E RICERCA LEGIONELLA
PER LA SICUREZZA DEGLI IMPIANTI IDRICI
La legionella è un batterio che vive in ambienti acquatici che può proliferare all’interno delle tubature degli impianti idrosanitari, soprattutto se il flusso d’acqua è assente o scarso. Inoltre, la presenza di calcare, ruggine o incrostazioni all’interno dell’impianto idrico favoriscono lo sviluppo del batterio, aumentando la probabilità di contaminazioni.
Contrastare il rischio di contaminazioni è importante perché la Legionella è uno dei patogeni più importanti trasmessi attraverso l’acqua e può causare infezioni all’apparato respiratorio anche gravi.
Quali sono le strutture più a rischio?
Il batterio della Legionella può proliferare in docce, rubinetti, impianti idrici, vasche idromassaggio, fontane decorative e altri impianti non adeguatamente mantenuti. Per questo motivo, il rischio di contaminazione da Legionella è più elevato per attività che osservano periodi di chiusura stagionale, o per le strutture dove gli impianti idrici sono particolarmente datati o rimangono inutilizzati per lunghi periodi.
Quali disturbi provoca la legionella?
Se l’uomo entra in contatto con il batterio della legionella può contrarre una forma grave di polmonite interstiziale. Questa patologia causa disturbi respiratori, tosse, febbre, mal di testa, dolori muscolari, perdita d’appetito, problemi renali e diarrea. Oppure si può prendere in maniera più lieve con una sindrome simil-influenzale.
Quando si sviluppa la Legionella?
- Quando la temperatura dell’acqua calda scende al di sotto di 50°C e quella dell’acqua fredda sale al di sopra di 20°C.
- Il flusso nel sistema idrico è scarso o assente
- L’acqua in ingresso è di scarsa qualità, non sottoposta ad adeguato trattamento di potabilizzazione, o è erogata con un regime di flusso intermittente.
- I materiali utilizzati favoriscono la formazione di nicchie protettive o il rilascio di nutrienti per la crescita e la formazione di biofilm.
- Presenza di fanghi, incrostazioni, ruggine, alghe e depositi organici che possono accumularsi lungo le tubazioni del sistema e nei serbatoi d’acqua.
- L’acqua in ingresso è di scarsa qualità, non sottoposta ad adeguato trattamento di potabilizzazione, o è erogata con un regime di flusso intermittente.

Cosa fare per prevenire?
- Verificare la corretta circolazione dell’acqua calda in tutte le parti del sistema idrico e la temperatura.
- Pulire, disincrostare e, all’occorrenza, sostituire tutti i terminali (docce e rubinetti) di acqua calda e fredda
- Assicurarsi che i serbatoi di stoccaggio dell’acqua potabile contengano cloro residuo libero ma non quantità eccessive che ne alterano la potabilità.
- Monitorare le temperature e i livelli di biocida per almeno 48 ore apportando, se necessario, opportune regolazioni.
- Controllare anche gli altri impianti a rischio, come impianti di condizionamento e le vasche idromassaggio
Come risolvere il problema?
Eseguire una corretta manutenzione e controlli periodici sugli impianti sono azioni importanti per prevenire l’insorgenza di contaminazioni.
IeS svolge prelievi e analisi complete per la Legionella e la potabilità dell’acqua. Si possono svolgere due tipologie di prelievo:
- Prelievo singolo: Si analizza il punto d’uscita del sifone al piano più alto della struttura
- 3 prelievi: La prima analisi viene fatta nel punto di raccolta, la seconda analisi si svolge a valle, nel serbatoio di acqua calda e la terza analisi viene fatta nel punto d’uscita al piano più alto. I 3 prelievi sono il metodo più accurato per rilevare la Legionella.
Eseguiti i prelievi, IeS svolgerà le analisi di laboratorio e, attraverso un rapporto di prova, darà evidenza dei risultati. In caso di valori fuori limite, sarà necessario valutare gli ulteriori accertamenti da eseguire per stabilire il livello di contaminazione delle acque e individuare le possibili linee di intervento.
Richiedi un controllo dell'acqua
Non sottovalutare il rischio di contaminazione da Legionella. Contattaci subito per un controllo. Compila i campi qui sotto oppure chiamaci: 0471 301611